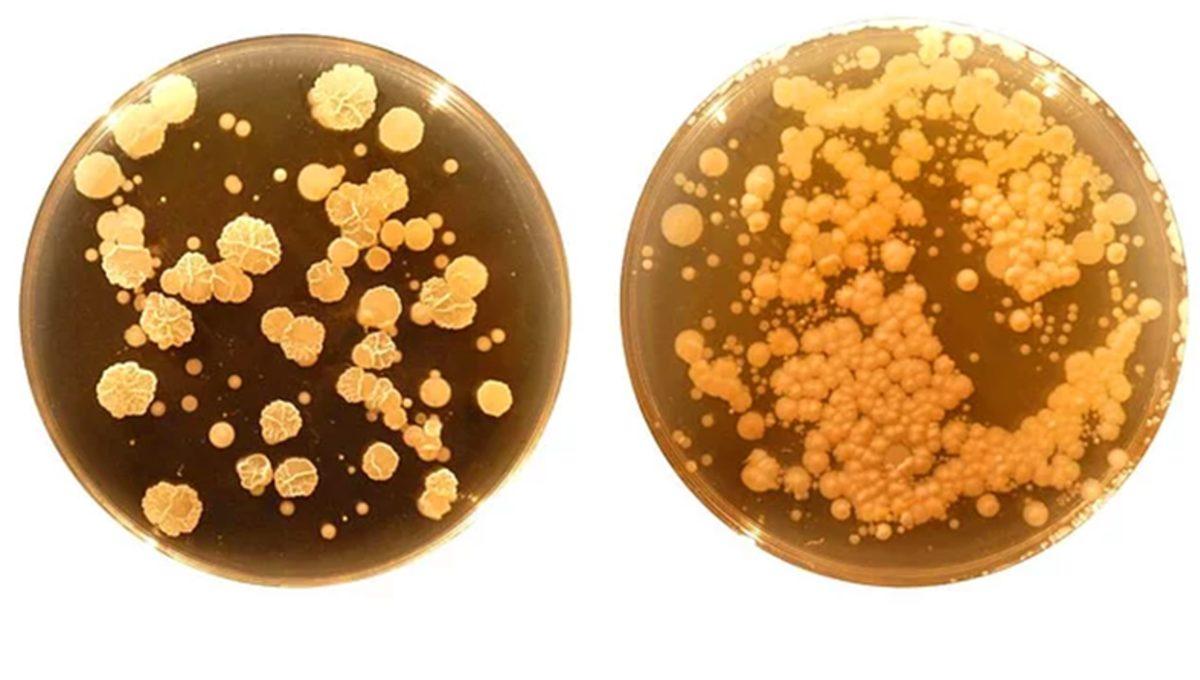
Vücudumuzun En Kirli Noktasının Neresi Olduğunu Biliyor muydunuz?
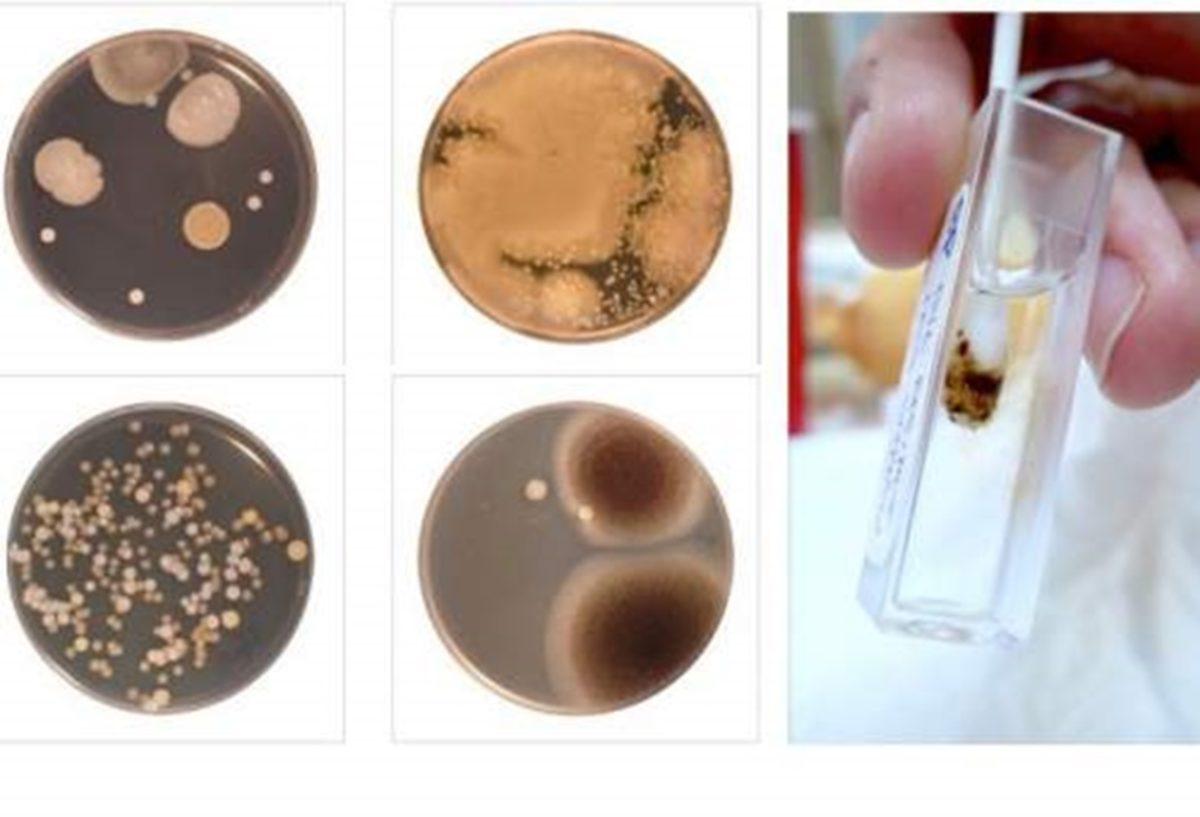
Vücudumuzun En Kirli Noktasının Neresi Olduğunu Biliyor muydunuz?

Uzmanlar, barındırdığı 2,368 farklı çeşit bakteri türü ile göbek deliğimizin vücudumuzun en pis noktası olduğunu bildiriyor. Genellikle göz ardı ettiğimiz göbek deliği temizliğimiz ise aslında oldukça önem taşımakta olduğunu ifade etmekteler.

İçerikten Görseller
Göbek deliklerimiz, günlük yaşantımız boyunca pamukçuk, ter, kir, ölü deri ve çeşitli bakterileri içine toplamaya eğimli. Malesef duşta hızlı bir biçimde yıkamak onu pek temiz kılmamakta. Temizlenip bakterilerden arınabilmesi için, biraz daha özel bir çaba gerekiyor.
Geçtiğimiz dönemde yapılan bir araştırmada uzmanlar, bilim dünyasının ilk defa karşılaştığı sadece göbek deliklerimize özel pek çok yeni bakteri türü buldular. Çalışmayı sürdüren Kuzey Karolina Eyalet Üniversitesi'nden profesör Rob Dunn ve ekibi, bugüne dek göbek deliklerimizde yaklaşık 1000 civarı bakteri türü olduğunu tahmin ederlerken, sürdürdükleri çalışma ile listeye yeni 1500 civarında bakteri türünün eklendiğini belirtip; deliğin 2368 farklı bakteriye ev sahipliği yaptığını ifade ediyorlar.
Peki bu kirli bölgenin temizliğini nasıl sağlayabiliriz? Uzmanlar bölgeyi en iyi tuzlu su ile temizleyebileceğimizi ifade etmekteler. Çünkü tuzun içinde bulunan klor elementi, bakterilerin üremesini engelleyen mikropları öldürmesiyle biliniyor. Göbek deliğimizi daha temiz bir yer haline getirmek için ayrıca bir parça pamuğa döktüğümüz alkol ile bölgeyi temizlemek, deliğimizde yaşamlarını süren bakterilerden kurtulmanın da bir diğer yolu.
